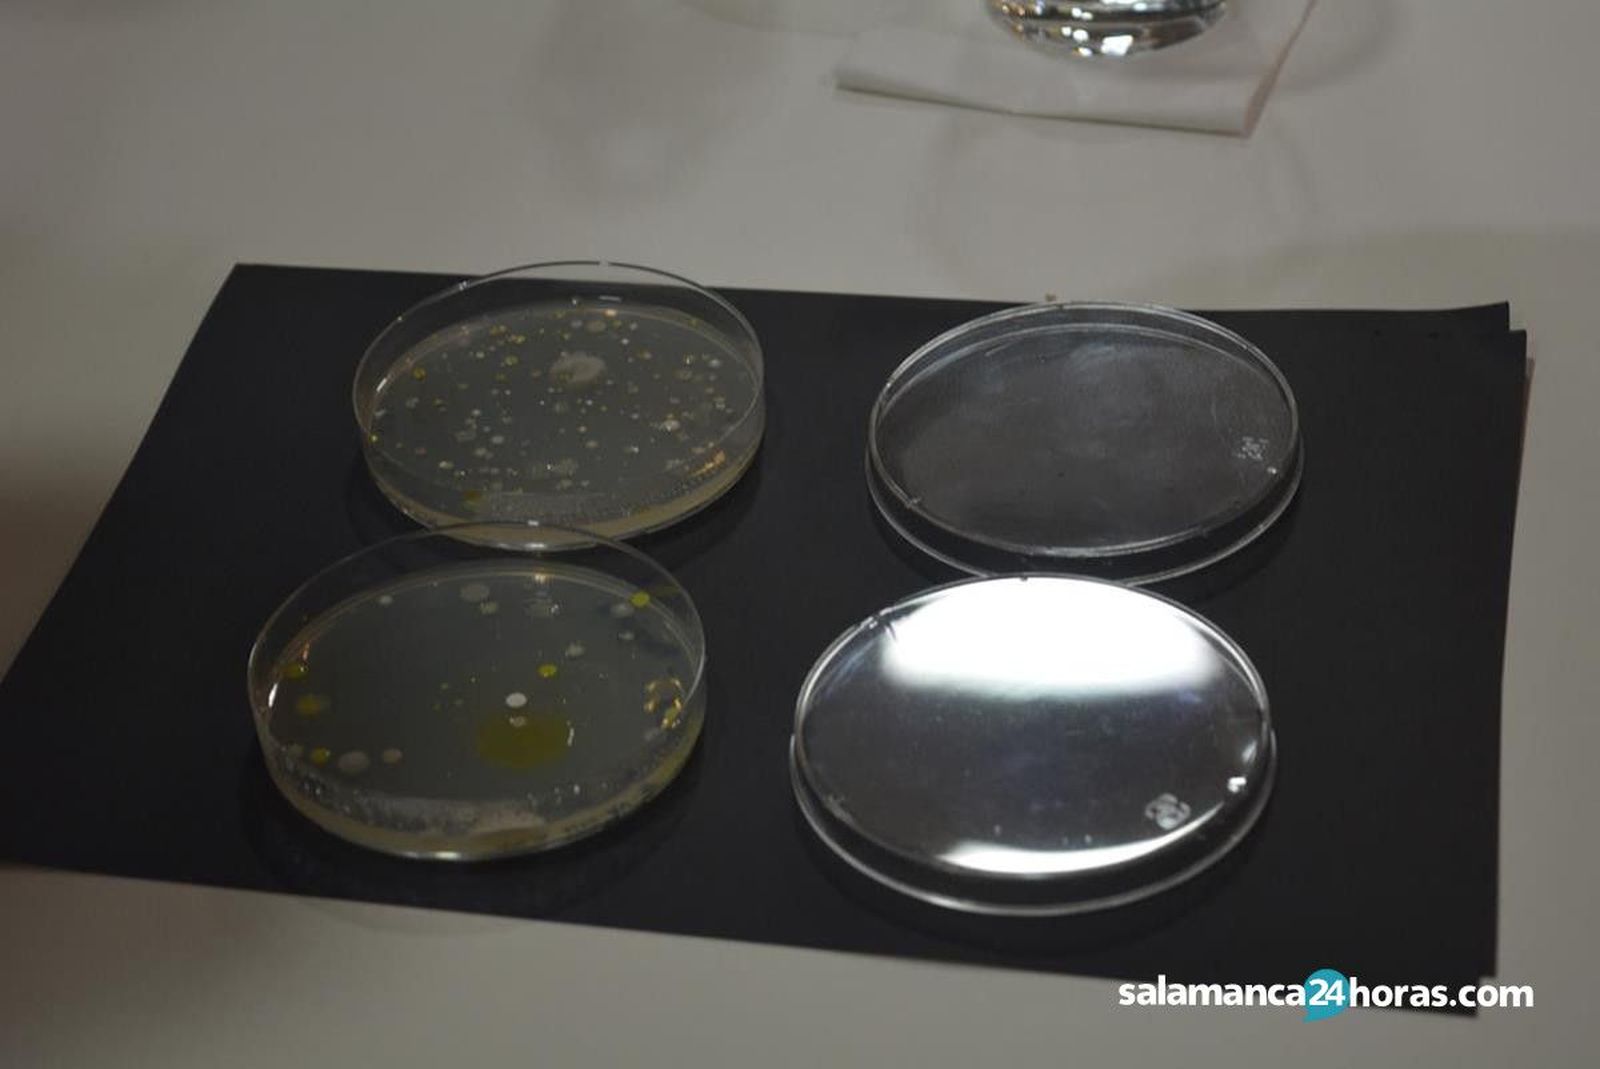
1661440

Presentación `Small World Initiative´

También te puede interesar
Lo último
